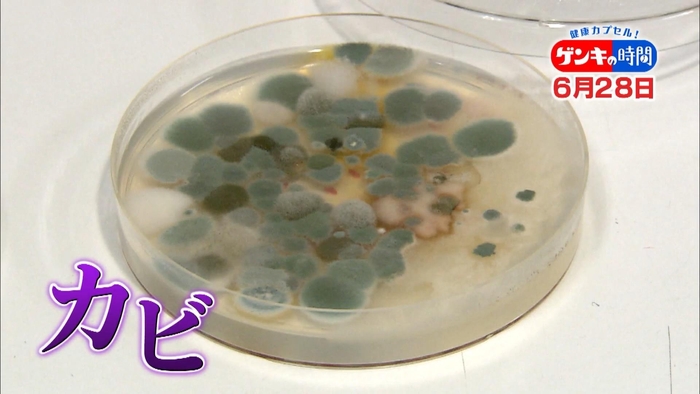

重大な感染症を招く恐れ…「カビ」が潜む意外な場所や手軽にできる除菌法・予防掃除術をご紹介!6月28日(日)あさ7:00放送『健康カプセル!ゲンキの時間』
今回のテーマは「カビが感染症を招く!おうちの除菌と予防掃除術」
2020年6月28日(日)あさ7:00放送 『健康カプセル!ゲンキの時間』
身近な健康問題とその改善法を、様々なテーマで紹介します。
MCは筧利夫と西尾由佳理。
今週のゲストは佐藤仁美さんです。
梅雨時の今、増えてくるのが「カビ」。
放置しておくと、重大な感染症を招く恐れがあるのです。
今回は、家の「カビ」が引き起こす病気を専門家が解説。
「カビ」が潜む意外な場所や手軽にできる除菌法と予防掃除術を紹介します。
今回のテーマは「カビが感染症を招く!おうちの除菌と予防掃除術」
放っておくと感染症の原因に…
カビ2大スポット「キッチン」「お風呂場」

傷口から体内に入ると脳や臓器を侵す!危険なカビが潜むキッチンの意外な場所とは?

お風呂を掃除してもカビが生えてくる!その原因は「天井」にあり!?
そしてお風呂場にはもう1つ見逃しがちなポイントが…
咳や痰が止まらなくなり呼吸困難!怖い菌が潜むお風呂のある場所とは?
さらにある一手間で大掃除いらず。
何度も掃除しなくてもOK!マスキングテープを使った予防掃除術とは?

これでカビ知らず!予防掃除術をご紹介!

その他にもポイントをご紹介!
▼エアコンは要注意!家の黒いカビが引き起こす「夏型過敏性肺炎」とは?
【ゲンキの時間PR動画】
『健康カプセル!ゲンキの時間』

身近な健康問題とその改善法を、様々なテーマで紹介します。
2012年にスタートした「健康カプセル!ゲンキの時間」。
2019年4月からは、新MCに筧利夫と西尾由佳理が就任、
専門ドクターから学んだすぐに役立つ健康情報をお届けします!
楽しい日曜の朝をこの番組と一緒に過ごしませんか?
【放送日】2020年6月28日(日)
【時間】あさ7:00
【出演】MC:筧利夫 西尾由佳理
ゲスト:佐藤仁美
ゲンキリサーチャー:くわばたりえ(クワバタオハラ)
ドクター:矢口貴志 ほか
【テーマ】「カビが感染症を招く!おうちの除菌と予防掃除術」
【番組HP】https://hicbc.com/tv/genki/?ref=pr2
※番組ホームページでは放送後、放送内容のアーカイブ情報が更新されます。
[ 番組HPトップページ ] > [ アーカイブ ] からご覧になれます。
CBCテレビ製作/TBS系28局ネット